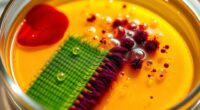
enzymes break down stains

If you’re looking for the best gravity water filters for backpacking, I recommend checking out models like the Waterdrop Gravity Straw and Platypus GravityWorks, which are easy to set up and highly effective. They offer large capacities to keep you hydrated in remote spots and are designed for rugged outdoor use. Keep in mind factors like flow rate, filter lifespan, and portability—these details can make all the difference. If you want to discover more top options and features, there’s plenty to explore ahead.
Key Takeaways
- Evaluate filtration capacity, flow rate, and lifespan to ensure the filter meets your hydration needs during extended trips.
- Choose models with multi-stage filtration, including activated carbon and ultrafiltration, for effective removal of bacteria, protozoa, and contaminants.
- Prioritize lightweight, compact designs with easy setup and maintenance features like backwash functions for convenience.
- Consider versatility with hanging options, extension tubes, and compatibility with water bottles or bags for various outdoor scenarios.
- Review user feedback and product standards to select reliable filters that deliver safe, clean water in remote or emergency situations.

Waterdrop Gravity Water Filter Straw, Camping Water Filtration System, Water Purifier Survival for Travel, Backpacking and Emergency Preparedness, 1.5 gal Bag, 5 Stage Filtration, Pack of 1
5-Stage Efficient Filtration: With adoption of premium-quality 0.1 um ultrafiltration membrane and other raw materials, the Water Filter...
As an affiliate, we earn on qualifying purchases.
Waterdrop Gravity Water Filter Straw, Camping Water Filtration System

If you’re looking for a reliable, portable water filtration solution for outdoor adventures or emergencies, the Waterdrop Gravity Water Filter Straw is an excellent choice. It includes a 1.5-gallon gravity-fed water bag and a multi-stage filtration straw that effectively reduces chlorine, sediment, bad taste, and odors. The filter uses a 5-stage process with coconut shell activated carbon and a 0.1-micron ultrafiltration membrane, providing safe drinking water for up to 1,400 gallons. Its backwash function keeps it clean, and the system easily connects to water bottles or bags. Compact and versatile, it’s perfect for camping, travel, or emergency preparedness.
Best For: outdoor enthusiasts, campers, travelers, and emergency preppers seeking a reliable portable water filtration system.
Pros:
- Effective 5-stage filtration using coconut shell activated carbon and ultrafiltration membrane for clean, safe water.
- Large 1.5-gallon gravity-fed water bag suitable for all-day hydration needs.
- Reusable and equipped with a backwash function to maintain filter performance and extend lifespan.
Cons:
- Setup requires opening the drainage valve to release air, which may be inconvenient for some users.
- The filter capacity of 1,400 gallons, while substantial, may still require replacement over extended use.
- The system’s reliance on gravity may be less practical in extremely remote locations without a stable setup area.

Waterdrop Gravity Water Filter Straw, Camping Water Filtration System, Water Purifier Survival for Travel, Backpacking and Emergency Preparedness, 1.5 gal Bag, 5 Stage Filtration, Pack of 2
5-Stage Efficient Filtration: With adoption of premium-quality 0.1 um ultrafiltration membrane and other raw materials, the Water Filter...
As an affiliate, we earn on qualifying purchases.
Waterdrop Gravity Water Filter Straw (Pack of 2)

The Waterdrop Gravity Water Filter Straw (Pack of 2) stands out as an ideal choice for outdoor enthusiasts and emergency preppers who need reliable, portable water filtration. Its 5-stage system effectively reduces chlorine, dirt, odors, and particulates, delivering up to 1,400 gallons of clean water. The reusable straw features a backwash purifier function for easy maintenance, and both ends disassemble for versatile connection and cleaning. The 1.5-gallon gravity bag provides enough capacity for all-day use, making it perfect for camping, hiking, or emergencies. Lightweight and user-friendly, this system requires no electricity, ensuring effortless access to safe drinking water whenever you need it.
Best For: outdoor enthusiasts, travelers, and emergency preppers seeking a reliable, portable water filtration solution for all-day use and various water sources.
Pros:
- 5-stage filtration effectively reduces chlorine, particulates, odors, and bad taste for clean, safe water.
- Reusable straw with backwash function simplifies maintenance and prolongs filter lifespan.
- Large 1.5-gallon gravity bag provides ample capacity for extended outdoor activities or emergencies.
Cons:
- The system’s weight may be considerable when fully filled, potentially affecting portability.
- Disassembly and cleaning require some effort, especially after muddy or stormwater sources.
- Filter lifespan of up to 1,400 gallons may necessitate replacement if used frequently over time.

Platypus GravityWorks Group Camping Water Filter System, 6-Liter
High-capacity, gravity-fed, hollow-fiber water filter system ideal for group and family camping, outdoor adventures, and emergency preparedness
As an affiliate, we earn on qualifying purchases.
Platypus GravityWorks Group Camping Water Filter System

The Platypus GravityWorks Group Camping Water Filter System stands out as an ideal choice for outdoor enthusiasts and groups who need reliable, high-capacity water filtration. It’s a lightweight, compact, gravity-fed system that filters up to 1,500 gallons, removing nearly all bacteria and protozoa. Simply scoop contaminated water into the dirty reservoir, hang it above the clean one, and let gravity do the work—filling the clean reservoir in just 2.5 minutes. Easy to operate, quick to backflush, and durable, it’s perfect for group camping, emergency prep, or long trips where large amounts of clean water are needed effortlessly.
Best For: groups, families, and outdoor enthusiasts seeking a reliable, high-capacity, and easy-to-use water filtration system for camping, emergency preparedness, or long outdoor trips.
Pros:
- High-capacity filtration of up to 1,500 gallons, suitable for large groups or extended use
- Easy gravity-fed operation with no need for pumps, batteries, or chemicals
- Compact, lightweight design that fits into a one-liter bottle, making it portable and convenient
Cons:
- Filter can be damaged if frozen below 32°F or dropped, requiring careful handling
- Hanging points like trees are necessary for optimal operation, which may not always be available
- The dirty water reservoir can be challenging to close in cold conditions or when full

Gravity Water Filtration System – 2 High Capacity Lightweight Hanging Bags for Backpacking, Camping, Survival, Hiking, Hunting - Dirty, Clean Water Bags, Water Filter and Cleaning Plunger Included
High Capacity Gravity Filtration System: Our filter in this pack removes >99.99% of waterborne bacteria (such as E....
As an affiliate, we earn on qualifying purchases.
Gravity Water Filtration System with 2 High Capacity Lightweight Hanging Bags

For outdoor enthusiasts seeking a reliable, high-capacity water filtration solution, the Gravity Water Filtration System with two lightweight hanging bags stands out. It effectively removes over 99.99% of bacteria, parasites, and microplastics down to 0.1 micron, providing nearly 10 years of safe drinking water for the average user. Weighing less than a pound, its compact design fits easily into backpacks or hydration setups. Each bag holds 6 liters, and setup takes less than a minute—just fill, hang, connect, and let gravity do the work. Made with durable, puncture-resistant materials, it’s perfect for camping, survival, or emergency prep.
Best For: outdoor enthusiasts, campers, hikers, hunters, and emergency preppers seeking a reliable, high-capacity water filtration system that is lightweight and easy to use.
Pros:
- Effectively removes over 99.99% of bacteria, parasites, and microplastics down to 0.1 micron
- Ultralight, compact design weighing less than a pound, ideal for backpacks and hydration setups
- Quick setup in under 60 seconds with durable, puncture-resistant materials
Cons:
- Slightly bulky for day hikes due to the size of the hanging bags
- Minor leaks in the clean water container reported by some users, fixable with Teflon tape
- Limited to 6-liter capacity per bag, which may require multiple fills for larger groups
Katadyn Gravity BeFree 3.0L Water Filter

If you’re looking for a lightweight, fast, and reliable gravity water filter for solo adventures or small groups, the Katadyn Gravity BeFree 3L system stands out. It uses advanced 0.1-micron hollow fiber technology to remove harmful organisms, surpassing EPA standards. The collapsible, BPA-free soft flask is durable, portable, and easy to fill, while the flow rate of 2 liters per minute guarantees quick access to clean water. Capable of filtering up to 1,000 liters, it’s perfect for camping, hiking, or emergencies. Its high-tech design and simple maintenance make it a favorite among outdoor enthusiasts seeking efficiency and ease of use.
Best For: solo travelers, hikers, and small groups seeking a lightweight, fast, and reliable gravity water filter for outdoor adventures or emergency preparedness.
Pros:
- Fast flow rate of 2 liters per minute for quick access to clean water
- Easy to clean with the EZ-Clean Membrane, prolonging filter lifespan
- Compact, lightweight, and portable design with a durable BPA-free soft flask
Cons:
- Water bag can be prone to damage if mishandled or overfilled
- May develop a metallic or plastic taste if not cleaned properly before storage
- Some users reported missing accessories like hoses or valves affecting usability
SimPure Gravity Water Filter with 3L Bag and Accessories

When camping, hiking, or facing emergency situations, having a reliable water filtration system is essential, and the SimPure Gravity Water Filter with 3L bag and accessories stands out as a versatile choice. It features a 3L TPU bag, tree strap, and extension tube, allowing for flexible water sourcing. The filter uses advanced technology, removing over 99.99999% of contaminants, including heavy metals, chlorine, and pathogens, from natural water sources. With a flow rate of 27 liters per hour and a lifespan of up to 5,000 liters, it’s lightweight, easy to use, and perfect for outdoor adventures or emergencies. Its durability and high performance make it a top option.
Best For: outdoor enthusiasts, campers, hikers, and emergency preppers seeking a reliable, portable water filtration solution for natural water sources.
Pros:
- Highly effective filtration removing over 99.99999% of contaminants, including heavy metals, chlorine, and pathogens
- Portable and lightweight design (2.8 ounces) with a compact 3L bag, ideal for backpacking and emergency kits
- Easy to set up, use, and clean, with a quick flow rate of 27 liters per hour and a lifespan of up to 5,000 liters
Cons:
- Initial filling can be tricky and may require some effort to clear bubbles for optimal flow
- Slow drip during operation, which might be inconvenient for quick water access
- Replacement filters may be needed over time, adding to maintenance considerations
Waterdrop Gravity Water Filter Straw for Camping and Emergency

The Waterdrop Gravity Water Filter Straw stands out as an essential tool for outdoor enthusiasts and emergency preppers alike. It’s a portable, multistage filtration system with a 0.1-micron ultrafiltration membrane that removes chlorine, sediment, bad taste, and odors, ensuring safe drinking water. The included 1.5-gallon gravity-fed bag can supply enough water for all-day use, filtering up to 700ml per minute with a lifespan of 1,400 gallons. Its versatile design connects easily to water bottles or bags, and it’s simple to clean and backwash. Lightweight and durable, it’s perfect for camping, hiking, or emergency scenarios where reliable, clean water is essential.
Best For: outdoor enthusiasts, emergency preppers, and travelers seeking a reliable, portable water filtration solution for natural water sources and emergency situations.
Pros:
- Effectively removes chlorine, sediment, bad taste, and odors with a 0.1-micron ultrafiltration membrane
- Large 1.5-gallon gravity-fed bag provides all-day water supply for groups or extended use
- Easy to clean, backwash, and connect to various water bottles or bags for versatile outdoor application
Cons:
- Filtering speed can be slow at times, especially with highly turbid water
- Valve wear or minor leaks may occur with frequent use or rough handling
- The yellowish tint from natural tannins can affect water appearance, though it remains safe to drink
MSR AutoFlow XL 10-Liter Backcountry Gravity Water Filter

The MSR AutoFlow XL 10-Liter Backcountry Gravity Water Filter stands out as an ideal choice for larger backpacking groups and basecamps that need a reliable, high-capacity water filtration system. It filters water at 1.75 liters per minute, removing 99.9999% of bacteria and 99.9% of protozoa, dirt, and debris. Its durable 3D film reservoir resists wear, and it’s easy to clean for long-term use. Weighing only 12 ounces and compact when packed, it’s convenient to carry. With a quick setup, separate hang strap, and environmentally friendly features, the AutoFlow XL offers a dependable, efficient solution for bulk water needs in the backcountry.
Best For: large backpacking groups and basecamps seeking a high-capacity, reliable gravity water filtration system for outdoor adventures.
Pros:
- High-capacity filtration with a flow rate of 1.75 liters per minute, suitable for multiple users.
- Durable, easy-to-clean 3D film reservoir with wear-resistant features.
- Lightweight and compact design with environmentally friendly, water-repellent storage bag.
Cons:
- Only available as a single unit, which may limit options for multi-filter setups.
- Slightly heavier than smaller portable filters, at 12 ounces.
- May be overkill for solo travelers or small groups with minimal water needs.
Gravity Water Filter System with 2-Gallon Bag & 0.1-Micron Water Filter Straw

Looking for a reliable gravity water filter system that can handle large groups or extended trips? This system features a 2-gallon bag and a 0.1-micron straw, perfect for camping, backpacking, or emergencies. Simply fill the reservoir, hang it, and let gravity do the work—no pumping needed. The 0.1-micron hollow fiber membrane filter removes 99.9999% of harmful substances, microplastics, and debris, providing up to 1,300 gallons of clean water. Made from durable materials resistant to punctures, it’s built for rugged outdoor use. Versatile and compatible with standard bottles, it offers quick, safe hydration wherever you are.
Best For: outdoor enthusiasts, large groups, or emergency preparedness individuals seeking a reliable, high-capacity water filtration system for extended trips or survival situations.
Pros:
- Capable of filtering up to 1,300 gallons of water, ideal for long-term use or large groups
- Removes 99.9999% of harmful substances, microplastics, and debris with a 0.1-micron filter for safe drinking water
- Durable, puncture-resistant materials suitable for rugged outdoor conditions and easy to hang for convenience
Cons:
- May be bulkier than smaller, individual filtration devices, affecting portability
- Requires hanging for optimal filtration, which might be challenging in some settings
- Limited compatibility with non-standard bottles or containers outside of the specified thread sizes
LifeStraw Peak Series Compact Gravity Water Filter System

If you need a versatile and lightweight gravity water filter for backpacking or group adventures, the LifeStraw Peak Series Compact Gravity Water Filter System is an excellent choice. It’s compact, weighing just around 1.5-2 oz less than competitors, and can be used as a gravity system, squeeze bottle, straw, or with standard bottles. Designed for small groups, it’s easy to set up in remote or backcountry environments. The durable materials assure it withstands tough conditions, while the high-performance filter removes 99.999999% of bacteria, parasites, microplastics, and silt. Its quick flow rate and compatibility with common bottles make it a reliable, versatile option for outdoor hydration.
Best For: outdoor enthusiasts, backpackers, and small groups seeking a lightweight, versatile water filtration system suitable for remote environments, travel, and backcountry adventures.
Pros:
- Ultra-lightweight and compact, weighing about 1.5-2 oz less than competitors, ideal for backpacking and travel.
- Versatile setup options including gravity, squeeze, straw, and standard bottle compatibility for various scenarios.
- High filtration effectiveness, removing 99.999999% of bacteria, parasites, microplastics, and silt, ensuring safe drinking water.
Cons:
- Potential clogging or flow slowdown when filtering very dirty or muddy water, which can take up to 30-45 minutes for 3 liters.
- Lack of caps or covers for the filter, requiring extra care during transport and storage, especially in freezing conditions.
- Cleaning the bladder can be challenging if mold or residue develops, as it does not include a cleaning tool or brush.
Sawyer Products One-Gallon Gravity Water Filtration System
https://m.media-amazon.com/images/I/61Ybh0m9wuL._AC_SX679_.jpg
For outdoor enthusiasts seeking a lightweight, reliable water filtration solution, the Sawyer Products One-Gallon Gravity Water Filtration System stands out with its compact design and high-performance 0.1-micron filter. It includes a 1-gallon reservoir, a wide-mouth bladder for quick filling, and a gravity hose with adapters, making setup effortless. The filter effectively removes bacteria, protozoa, and sediment, ensuring safe drinking water in the backcountry or emergencies. Weighing just 2 ounces, it’s easy to carry and highly versatile. With components tested three times for quality, this system offers a dependable, straightforward way to access clean water during outdoor adventures or survival situations.
Best For: outdoor enthusiasts, campers, and emergency preparedness individuals seeking a lightweight, reliable water filtration system for safe drinking water during outdoor activities or emergencies.
Pros:
- Compact and lightweight design (weighs only 2 ounces) for easy portability
- Effective 0.1-micron filter removes bacteria, protozoa, and sediment
- Includes comprehensive components like a 1-gallon reservoir, wide-mouth bladder, and adapters for versatile use
Cons:
- Requires setup and priming, which may be inconvenient in urgent situations
- Limited to gravity-based filtration, possibly slower compared to pump systems
- Replacement filters may be needed over time, adding ongoing costs
Ultra Gravity Water Bag for Water Filtration Systems

The Ultra Gravity Water Bag stands out as an ideal choice for outdoor enthusiasts who need a reliable, portable water storage solution that seamlessly integrates with common filtration systems. Its 8-liter capacity makes it perfect for camping, hiking, or backpacking adventures, while its lightweight design (just over 12 ounces) ensures easy transport. Made from food-grade, BPA-free TPU, it’s durable, foldable, and collapsible, with a wide-mouth opening for quick filling and cleaning. The bag supports gravity-fed filtration by hanging, and includes essential accessories like a hose, flow regulator, and adjustable strap. It’s versatile, reusable, and built to handle off-grid scenarios effortlessly.
Best For: outdoor enthusiasts, campers, hikers, and backpackers seeking a portable, durable water storage and filtration solution for off-grid and emergency situations.
Pros:
- Made from food-grade, BPA-free TPU ensuring safe and durable use.
- Large 8L capacity with foldable and collapsible design for easy transport and storage.
- Compatible with various filtration systems and includes essential accessories for versatile use.
Cons:
- Slightly heavier than some ultra-lightweight water containers, at approximately 12.6 ounces.
- Requires hanging and gravity-fed setup, which may not be suitable for all environments.
- Limited color options and may need manual cleaning to prevent mold or residue buildup.
Platypus, GravityWorks Filter Cartridge

The Platypus GravityWorks Filter Cartridge stands out as an excellent choice for outdoor enthusiasts who need fast, reliable water purification without the hassle of pumping. It features a hollow fiber design that removes 99.9% of protozoa and 99.9999% of bacteria, filtering water down to 0.2 microns. Certified by NSF and meeting EPA standards, it provides safe, great-tasting water for camping and backpacking. With a flow rate of 1.75 liters per minute and a lifespan of about 1,500 liters, it’s easy to use and maintain—just a quick backflush keeps it performing at its best. It’s a durable, efficient option for group adventures.
Best For: outdoor enthusiasts, campers, and backpackers seeking fast, reliable, and easy-to-maintain water purification without the need for pumping.
Pros:
- Fast flow rate of 1.75 liters per minute for quick water collection
- High filtration standards removing 99.9% protozoa and 99.9999% bacteria, ensuring safe drinking water
- Easy to use and maintain with simple backflushing to extend cartridge lifespan
Cons:
- Approximately 1,500-liter lifespan may require replacement for heavy users
- Does not include reservoirs or tubing, which are recommended for optimal system performance
- Potential clogging if not regularly maintained through backflushing, reducing flow rate
Waterdrop Gravity Water Bag for Camping

If you’re heading outdoors and need a reliable way to carry and filter water, the Waterdrop Gravity Water Bag for Camping stands out as an excellent choice. It’s a 1.5-gallon foldable container made from BPA-free, food-grade TPU, ensuring safe storage. Its wide opening makes filling easy, while the roll-top closure prevents leaks. The hard tube connects seamlessly to compatible filters like Waterdrop Filterstraw or Sawyer Mini, enabling quick, gravity-fed filtration. Lightweight at around 0.32 kg, it’s perfect for camping, backpacking, or emergencies. Its durable, flexible design allows for compact storage, making it a practical, versatile solution for large-volume water needs on outdoor adventures.
Best For: outdoor enthusiasts, campers, hikers, and emergency preppers needing a reliable, large-capacity water storage and filtration solution.
Pros:
- Large 1.5-gallon capacity ideal for extended outdoor activities and group use
- Made from BPA-free, food-grade TPU ensuring safe, durable water storage
- Compatible with popular filtration systems like Waterdrop Filterstraw and Sawyer Mini for quick, gravity-fed filtering
Cons:
- The stiff plastic tube may limit flexibility and ease of use
- The roll-top closure does not provide a completely sealed leak-proof solution during transport
- Some users report that the spring closure and clips may loosen or fail after prolonged use
Squeeze Water Filtration System

For outdoor enthusiasts seeking a lightweight, portable water filtration option, the Squeeze Water Filtration System by Sawyer Products stands out. Weighing just 3.2 ounces and fitting comfortably in your hand, it’s perfect for backpacking and travel. Its 0.1-micron filter removes nearly all bacteria, protozoa, and microplastics, ensuring safe drinking water. The system quickly filters up to 1.7 liters per minute, whether you squeeze the pouch or use gravity. It includes reusable 32-ounce pouches, a drinking straw, and adapters, making it versatile for various setups. Its compact size and ease of use make it a top choice for reliable, on-the-go filtration.
Best For: outdoor enthusiasts, backpackers, and emergency preppers seeking a lightweight, reliable water filtration system for on-the-go use.
Pros:
- Highly effective at removing bacteria, protozoa, and microplastics with a 0.1-micron filter.
- Lightweight and compact, weighing only 3.2 ounces, ideal for ultralight travel.
- Compatible with various water sources and setups, including bottles, hydration packs, and gravity systems.
Cons:
- Rigid, supplied bags can be cumbersome to fill and prone to damage; users often replace them.
- Regular maintenance like backflushing and bleaching is necessary to maintain optimal performance.
- Some users find the included accessories and filling options could be more durable or flexible.
Factors to Consider When Choosing Backpacking Water Filters Gravity

When choosing a gravity water filter for backpacking, I focus on how well it matches my water source and needs. Factors like filtration speed, capacity, ease of setup, and durability all influence how effective and convenient it will be on the trail. Considering these points helps me pick a filter that’s reliable and suits my adventure style.
Water Source Compatibility
Choosing a backpacking water filter requires guaranteeing it’s compatible with your water sources, such as lakes, rivers, streams, or ponds, which can vary widely in contaminant levels. Some filters handle turbid or muddy water better than others, so check if it’s rated for high sediment loads. Confirm the filter’s maximum TDS (total dissolved solids) level compatibility, usually up to 500 PPM, to prevent clogging or damage. Also, verify that the connection fittings match your water source, whether that’s standard threads for water bags, bottles, or inline setups. Consider whether the filter can handle your typical flow rate and the volume you’ll need to process. Ensuring compatibility helps you avoid surprises and ensures reliable, clean water during your trip.
Filtration Speed and Rate
Filtration speed plays a crucial role in selecting a backpacking water filter, as it determines how quickly you can access safe drinking water on your trip. A higher flow rate, like 2 liters per minute, means you spend less time waiting and can hydrate more efficiently, which is especially important during busy or hot days. The flow rate depends largely on the filter’s pore size; ultrafiltration membranes at 0.1 microns typically offer faster filtration without sacrificing safety. Slow filtration rates can cause fatigue and discourage proper hydration, particularly if multiple people rely on the same system. To keep the flow consistent, consider how resistant the filter is to clogging and how easy it is to backflush or clean. These factors ensure you get reliable, quick access to water throughout your trip.
Capacity and Volume
A water filter’s capacity and volume are crucial factors that directly influence your trip’s convenience and safety. Larger capacity filters, like those holding 2-3 gallons, are perfect for groups or longer trips, ensuring you have enough water without constant refills. Filters with a lifespan of 1,000 to 1,500 gallons or more offer long-term reliability, reducing the need for frequent replacements during extended hikes. The flow rate also matters, as it determines how quickly you can get water for drinking or cooking. Additionally, lightweight, collapsible bags with sufficient volume make transporting and storing water easier, especially when space and weight are limited. Matching your filter’s capacity with your hydration needs helps prevent running out of clean water, keeping your trip safe and hassle-free.
Ease of Setup
When selecting a gravity water filter, how easy it is to set up can make a big difference in your overall experience. I look for systems with simple, intuitive assembly that can be done in just a few minutes, saving time and frustration in the field. Clear, labeled connections and easy-to-operate valves help me start the flow quickly without confusion. I prefer gravity-fed systems that require minimal handling—just hang the reservoir and let gravity do the work—so I avoid manual pumping or complicated attachments. Quick-disconnect fittings or disassemblable parts are a bonus, making cleaning and maintenance straightforward. I also check user reviews and instructions to verify the setup process is clear, especially if I need to deploy the filter under outdoor or emergency conditions.
Durability and Materials
Choosing a durable backpacking water filter means paying close attention to the materials it’s made from, since rugged outdoor conditions can be tough on equipment. High-quality materials like BPA-free TPU, stainless steel, and reinforced plastics guarantee the filter can withstand impacts, UV exposure, and freezing temperatures without cracking or breaking. The filtration components, such as hollow fiber membranes or activated carbon layers, should resist clogging and keep performing over thousands of gallons—often up to 1,500 gallons or more. Materials used for the housing and hoses must be resilient to physical stress and leaks, with secure fittings and reinforced seams providing added durability. Some filters feature easy-to-clean designs or backflushing functions, extending their lifespan and maintaining performance in demanding outdoor environments.
Maintenance Requirements
Regular maintenance is crucial to keep gravity water filters working effectively during backpacking trips. I always backflush or rinse the filter with clean water to prevent clogging and ensure a steady flow. Following the manufacturer’s recommended cleaning routines, like using bleach solutions or specialized cleaning kits, helps extend the filter’s lifespan. Some filters require disassembly for thorough cleaning, which means having the right tools and extra time. I also inspect my filter regularly for damage, such as cracks or tears, replacing parts when needed to keep water safe. For turbid or heavily contaminated water sources, consistent cleaning and maintenance are especially important to preserve filtration efficiency. Proper upkeep ensures my filter performs reliably throughout my trip, providing clean water without fuss.
Weight and Portability
Lightweight and compact water filters make a significant difference on backpacking trips by reducing the load I carry and boosting mobility. Filters weighing under 2 ounces are ideal for keeping my pack light, especially on long hikes. Compact designs that fold or roll up, like TPU bags or soft flasks, help me save space and prevent bulk. Multi-use systems with detachable parts or collapsible reservoirs maximize capacity while staying portable. I always consider the overall weight, including hoses and accessories, to ensure it fits within my backpacking limits. Choosing a filter with a low weight and small size makes it easier to carry without sacrificing filtration performance. Ultimately, portability helps me stay agile and comfortable on the trail.
System Versatility
When selecting a gravity water filter, I consider how versatile it is across different situations and water sources. A flexible system can connect to various sources like lakes, streams, hydration packs, bottles, and bags, giving me multiple setup options. I look for filters with disassemblable parts that allow for backflushing and cleaning, which helps extend their lifespan and keeps the flow steady. Compatibility with accessories like extension tubes, adapters, and inline filters is also a plus, letting me customize my setup for different scenarios. Some filters can be used as squeeze, gravity, or straw systems, making them adaptable whether I’m solo, in a group, or in an emergency. Recyclable, pollution-free filters designed for long-term use add further versatility, filtering thousands of gallons across different water qualities.
Frequently Asked Questions
How Long Do Gravity Water Filters Typically Last Before Needing Replacement?
When it comes to how long gravity water filters last, it really depends on the model and usage. Generally, most filters can treat around 100,000 gallons before needing replacement. I always keep an eye on the filter’s lifespan and follow the manufacturer’s guidelines. Regular cleaning and maintenance help extend its life, so I make sure to replace the filter element when it reaches its limit to guarantee safe, clean water on my hikes.
Can Gravity Water Filters Remove Viruses From Contaminated Water Sources?
Think of a gravity water filter as a superhero cape—designed to protect you from unseen villains. While many filters effectively remove bacteria and protozoa, not all are guaranteed to eliminate viruses. I’ve seen some models tested for viruses, and it’s essential to choose one certified for virus removal. Always check product specs; if viruses are a concern, opt for filters with advanced treatment like UV or chemical purification to stay safe.
Are Gravity Water Filters Effective Against Chemical Pollutants and Heavy Metals?
You’re wondering if gravity water filters can tackle chemicals and heavy metals. I’ve found that most gravity filters are great for removing bacteria and protozoa, but they often don’t effectively filter out chemicals or heavy metals. For those contaminants, I recommend using additional treatments like activated carbon filters or chemical purifiers. Combining methods guarantees you get safe, clean water, especially in areas with chemical pollution.
What Is the Best Way to Clean and Maintain a Gravity Water Filter System?
When it comes to cleaning and maintaining my gravity water filter, I always start by backflushing it regularly to clear out debris. I also disassemble and scrub the filter components with a soft brush and mild soap every few weeks, avoiding harsh chemicals. After cleaning, I rinse everything thoroughly and let it dry completely before reassembling. Proper maintenance guarantees my filter stays effective and lasts longer on my backpacking trips.
How Do Weight and Packability Compare Among Different Gravity Filter Models?
When comparing gravity filter models, I find that lighter, more compact options really shine for backpacking. They’re easier to pack and carry without weighing you down, making your trek more enjoyable. Heavier models, while sometimes more durable, can slow you down and tire you out. I recommend balancing weight and packability based on your trip’s length and terrain. Ultimately, a lightweight filter makes staying hydrated less of a burden.
Conclusion
Imagine reaching that remote spring, knowing your water is pure and ready with just a simple setup. With these top gravity filters, you’re equipped to face any wilderness challenge. But which one will you choose to guarantee your hydration stays safe and effortless? The right filter could be your secret weapon in the wild, transforming a formidable task into a seamless part of your adventure. Are you ready to make your pick and conquer the trails?